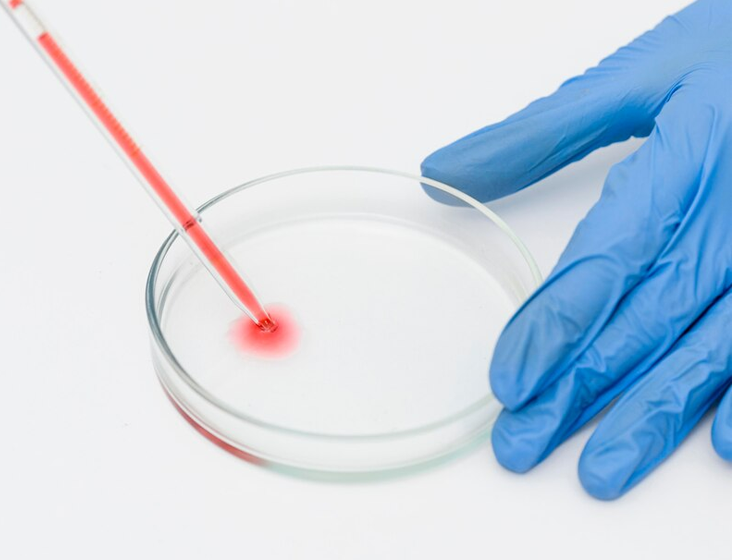

Providing high-quality technical services in physical, chemical, and microbiological analysis. Our services cover water and wastewater treatment, field sampling, and environmental testing. With a dedicated team, we strive for excellence and continuous growth from our humble beginnings.
Our laboratory is accredited by the South African National Accreditation System (SANAS), ensuring the highest quality results. Equipped with advanced technology and skilled personnel, we deliver accurate results within the required turnaround time.